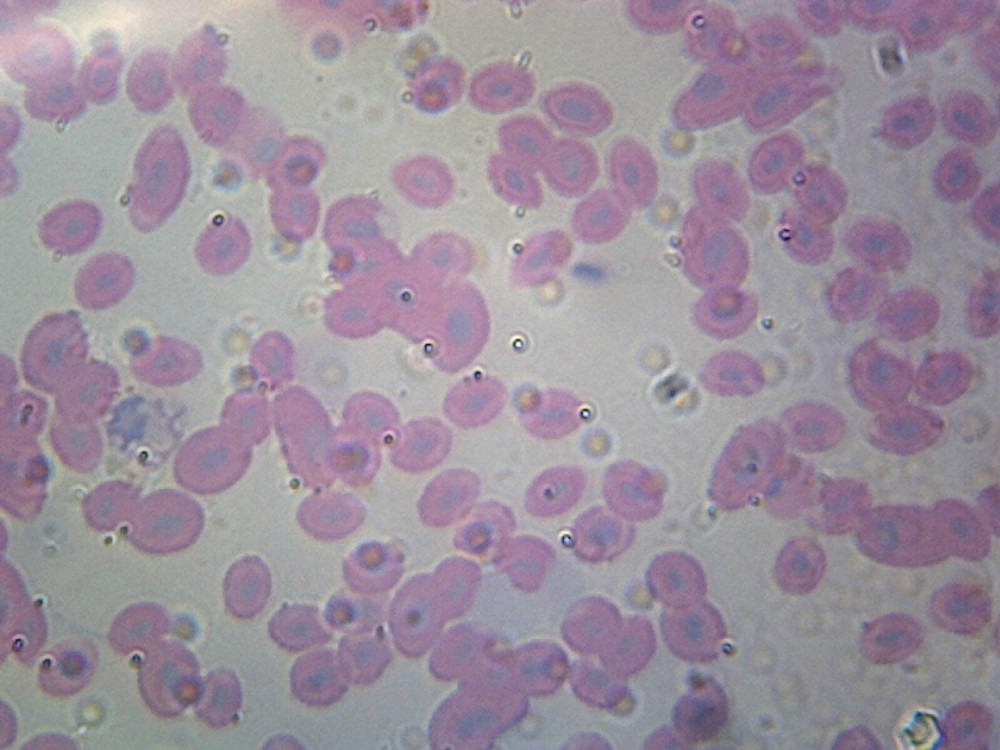
Fish Blood; Smear

| Brand | Celestron |
|---|---|
| MPN | 44410 |
| Department | Men |
| UPC | 050234444101 |
Check the listing for details. Celestron Prepared Microscope Slides Set - 25 Piece - 44410. Condition: New. Listed at 30.74 USD. Specification:Celestron 25 Piece Prepared Microscope Slides Set 44410. 44410 - Celestron 25 Piece Prepared Microscope Slides Set 25pc. Celestron Prepared Microscope Slides Set. Both the 25pc. slides set and 100pc.